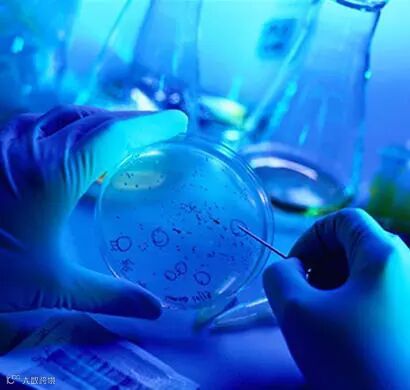

金库咨询服务
把入户给你最爱的人
11月26日,有新闻报道“世界首例免疫艾滋病的基因编辑婴儿在中国诞生”,文中称“一对名为露露和娜娜的基因编辑婴儿于11月在中国健康诞生,这是世界首例免疫艾滋病的基因编辑婴儿,也意味着中国在基因编辑技术用于疾病预防领域实现历史性突破”。

这个消息出来后迅速引起学术界的极大关注。
关注的重点是,这个研究是严重违背科学伦理学原则的,
甚至有人认为是大逆不道,或道德败坏到极点,是为了个人利益丧失人性的科学疯子。
01

这里需要我们认真思考的问题是,伦理学审查问题在国内的重视程度不够,伦理学问题在学术界存在混乱的问题。有人会认为,伦理学只对人类开展研究才存在,对动物实验就没有伦理学问题。
其实动物实验也一样有伦理学的问题,只是我们不够重视或不了解导致。

02

其实我们这里讨论的伦理学是医学伦理学。按照学术定义,医学伦理学是运用伦理学的理论、方法研究医学领域中人与人、人与社会、人与自然关系的道德问题的一门学问。
医学伦理学是运用一般伦理学原则解决医疗卫生实践和医学发展过程中的医学道德问题和医学道德现象的学科,它是医学的组成部分,又是伦理学的分支。
03

对涉及到人研究方面的伦理学主要有两个关键文件,分别是《纽伦堡法典》和《赫尔辛基宣言》。第二次世界大战时,德国纳粹分子借用科学实验和优生之名,用人体实验杀死了600万犹太人、战俘及其他无辜者,这些人被纳粹统称为"没有价值的生命"。
主持这次惨无人道实验的,除纳粹党官员外,还有许多医学教授和高级专家。德国战败后,这些为首分子被作为战犯交纽伦堡国际军事法庭审判,其中有23名医学方面的战犯。
同时,纽伦堡法庭还制定了人体实验的基本原则,作为国际上进行人体实验的行为规范,即《纽伦堡法典》,并于1946年公布于世。
《赫尔辛基宣言》全称《世界医学协会赫尔辛基宣言》,该宣言制定了涉及人体对象医学研究的道德原则, 是一份包括以人作为受试对象的生物医学研究的伦理原则和限制条件,也是关于人体试验的第二个国际文件,比《纽伦堡法典》更加全面、具体和完善。
简单的说,伦理学关注的是保护患者的利益。医学研究过程中,医学伦理学关注的重点是保护受试者的利益,避免受试者各个方面利益受到不合理侵犯。

04

最新这一事件中,为什么众多科学家都明确反对对人类胚胎进行编辑?这种基因编辑技术存在脱靶的风险,脱靶就是没有按照原来的设计目标破坏或编辑了其他基因,这样会导致人为的基因突变。其实这并不是重点,因为脱靶只是技术成熟度和技术稳定性问题。即使克服了这样的问题,例如可以对胚胎进行基因分析和基因诊断,排除脱靶带来的危险。仍然不能进行这样的基因编辑。
所以我们不能开展这样的技术,是我们对人类的基因编辑没有达到非常应用自如的程度。
如果我们能对人体内单细胞进行基因编辑,或对某类细胞进行基因编辑,例如我们只对CD4+淋巴细胞进行基因编辑,这样可以避免艾滋病进入这种特定的细胞,这样又不会给患者带来可遗传基因编辑,对受试者免疫功能也不会产生潜在危险。是不是就可以进行这样的编辑。其实基因治疗的策略就是对已经出生的患者进行基因修补编辑的工作,这方面的研究已经进入到临床应用,这说明技术本身并没有问题,关键是我们使用的场景,关键是我们对这种场景的控制能力不足。
反过来想想,这个人把自己的工作公开是‘’不错‘’的表现,如果采用不公开地秘密开展工作,让一大批被编辑改造的人类新生儿出生,这在技术上完全有可能,是不是更可怕更危险。所以从某种意义上讲,我们应该感谢这个公开声明的人。让大家立刻意识到这种问题的危害性,认识到我们在伦理学方面存在的可能漏洞。

往期精彩:
想了解更多“时讯”
长按关注服务号



